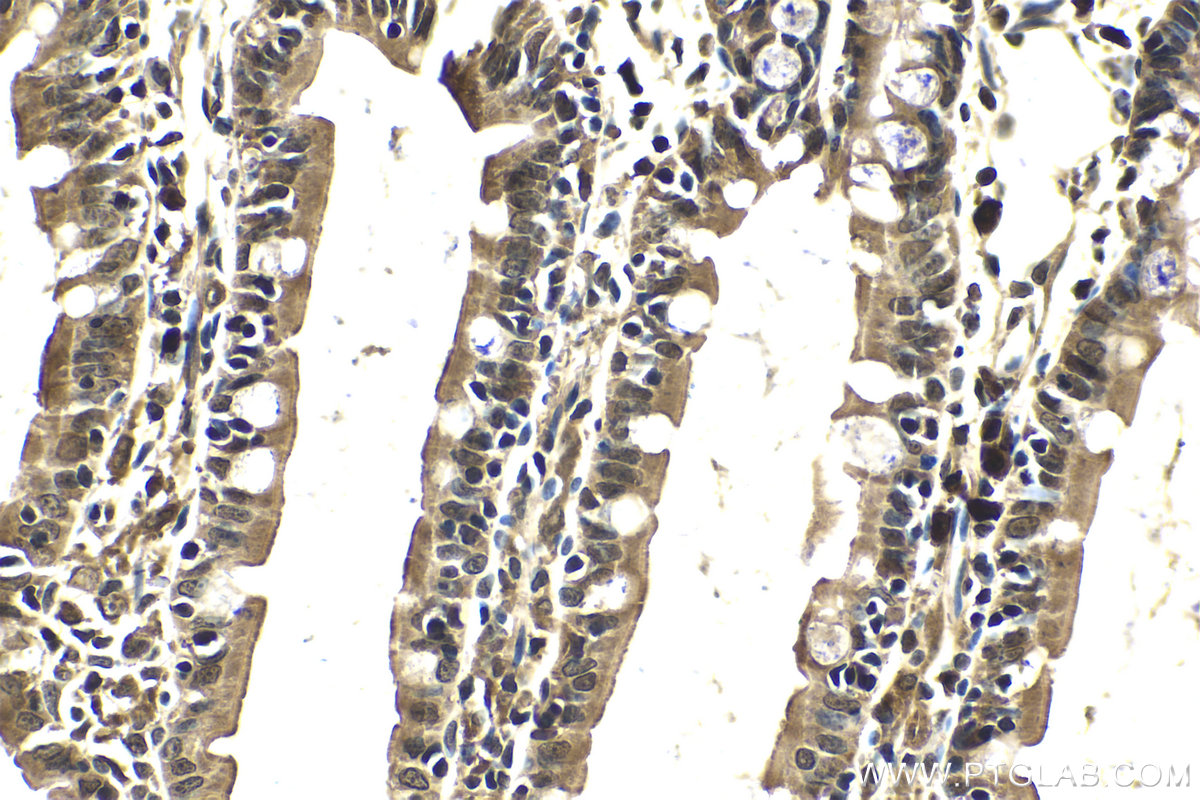

验证数据展示
经过测试的应用
| Positive WB detected in | K-562 cells, U-937 cells |
| Positive IHC detected in | human placenta tissue, mouse kidney tissue, mouse small intestine tissue, rat kidney tissue, rat small intestine tissue Note: suggested antigen retrieval with TE buffer pH 9.0; (*) Alternatively, antigen retrieval may be performed with citrate buffer pH 6.0 |
推荐稀释比
| 应用 | 推荐稀释比 |
|---|---|
| Western Blot (WB) | WB : 1:1000-1:4000 |
| Immunohistochemistry (IHC) | IHC : 1:250-1:1000 |
| It is recommended that this reagent should be titrated in each testing system to obtain optimal results. | |
| Sample-dependent, Check data in validation data gallery. | |
发表文章中的应用
| WB | See 5 publications below |
产品信息
25868-1-AP targets PI3 Kinase p85 Beta in WB, IHC, ELISA applications and shows reactivity with human, mouse, rat samples.
| 经测试应用 | WB, IHC, ELISA Application Description |
| 文献引用应用 | WB |
| 经测试反应性 | human, mouse, rat |
| 文献引用反应性 | human, mouse, rat |
| 免疫原 |
CatNo: Ag14369 Product name: Recombinant human PIK3R2 protein Source: e coli.-derived, PET28a Tag: 6*His Domain: 1-324 aa of BC014170 Sequence: YRHESLAQYNAKLDTRLLYPVSKYQQDQIVKEDSVEAVGAQLKVYHQQYQDKSREYDQLYEEYTRTSQELQMKRTAIEAFNETIKIFEEQGQTQEKCSKEYLERFRREGNEKEMQRILLNSERLKSRIAEIHESRTKLEQQLRAQASDNREIDKRMNSLKPDLMQLRKIRDQYLVWLTQKGARQKKINEWLGIKNETEDQYALMEDEDDLPHHEERTWYVGKINRTQAEEMLSGKRDGTFLIRESSQRGCYACSVVVDGDTKHCVIYRTATGFGFAEPYNLYGSLKELVLHYQHASLVQHNDALTVTLAHPVRAPGPGPPPAAR 种属同源性预测 |
| 宿主/亚型 | Rabbit / IgG |
| 抗体类别 | Polyclonal |
| 产品类型 | Antibody |
| 全称 | phosphoinositide-3-kinase, regulatory subunit 2 (beta) |
| 别名 | PI3K p85 β, PI3K p85(beta), PI3K p85β, PIK3R2, p85 |
| 计算分子量 | 728 aa, 82 kDa |
| 观测分子量 | 82 kDa |
| GenBank蛋白编号 | BC014170 |
| 基因名称 | PI3 Kinase p85 Beta |
| Gene ID (NCBI) | 5296 |
| RRID | AB_3669503 |
| 偶联类型 | Unconjugated |
| 形式 | Liquid |
| 纯化方式 | Antigen affinity purification |
| UNIPROT ID | O00459 |
| 储存缓冲液 | PBS with 0.02% sodium azide and 50% glycerol, pH 7.3. |
| 储存条件 | Store at -20°C. Stable for one year after shipment. Aliquoting is unnecessary for -20oC storage. |
背景介绍
PI3 Kinase p85 is also named as PIK3R2 and belongs to the PI3K p85 subunit family. PI3 Kinase p85 is a regulatory subunit of phosphoinositide-3-kinase (PI3K) which is a kinase that phosphorylates phosphatidylinositol 4,5-bisphosphate to generate PIP3. PI3 Kinase p85 binds to activated (phosphorylated) protein-tyrosine kinases through its SH2 domain, and then acts as an adapter to mediate the association of the p110 catalytic unit to the plasma membrane. It promotes nuclear translocation of XBP1 isoform 2 in a ER stress or insulin-dependent manner during metabolic overloading in the liver and hence plays a role in glucose tolerance improvement (PMID:23604317).
实验方案
| Product Specific Protocols | |
|---|---|
| IHC protocol for PI3 Kinase p85 Beta antibody 25868-1-AP | Download protocol |
| WB protocol for PI3 Kinase p85 Beta antibody 25868-1-AP | Download protocol |
| Standard Protocols | |
|---|---|
| Click here to view our Standard Protocols |
发表文章
| Species | Application | Title |
|---|---|---|
Front Pharmacol Aconiti Lateralis Radix Praeparata ameliorates heart failure via PI3K/AKT/Bnip3 pathway | ||
Pharmaceutics Molecular Target Identification of Gossypol Against Cervical Cancer Based on Target Fishing Technology | ||
Curr Issues Mol Biol The Antidiabetic Mechanisms of Cinnamon Extract: Insights from Network Pharmacology, Gut Microbiota, and Metabolites | ||
Nanomaterials (Basel) 2D MXene Nanosheets with ROS Scavenging Ability Effectively Delay Osteoarthritis Progression | ||